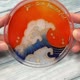

**【非物质文化遗产:掐丝珐琅】**
掐丝珐琅,是元朝成吉思汗西征时,于阿拉伯掳回当地工匠后所遗传下的工艺技术。最早的技法,是先以铜丝框格,填上各色的釉料,反复烧制后打磨、镀金而成;由于在明代景泰年间达到创作高峰,因此又称 景泰蓝。
我们提取掐丝珐琅的传统工法,以现代时尚的素材改良,不用烧制也可以体验当时的巅峰工艺!
https://cdn.store-assets.com/s/181647/f/13829561.png
https://cdn.store-assets.com/s/181647/f/14096037.jpg
**|入门体验可以学到什么?**
- 传统掐丝技巧
- 烧结彩砂填制与晕染技巧(现场 40 色选色)
- 正向肯定句英文字设计(英文字为贴纸)
**- 填胶封存:最后一步骤为填胶,需带回 24 小时胶水干燥后才能 100% 完成。**
- 完成作品:直径 10cm 玻璃制物盒 (含上盖) 一只
★ 老师会在现场视同学体验情况询问,是否需要改换成较简单的图稿进行!
**👩🎨 可定制化为礼物,如需完成品请私讯我们!**
https://cdn.store-assets.com/s/181647/f/11417424.jpg
https://cdn.store-assets.com/s/181647/f/11419053.jpg
https://cdn.store-assets.com/s/181647/f/11924855.jpeg
https://cdn.store-assets.com/s/181647/f/11419054.jpg
https://cdn.store-assets.com/s/181647/f/11924849.jpeg
**★注意事项:**
请您知悉:体验作品的最后一步骤为填胶,需带回 24 小时胶水干燥后才能 100% 完成。
https://cdn.store-assets.com/s/181647/f/11419059.jpg
**|学生评价:**
https://cdn.store-assets.com/s/181647/f/14976018.png
https://cdn.store-assets.com/s/181647/f/14976019.png
**|图案款式:**
现场开放提供多款图案挑选,‘无法’自绘图案以利课程时间进行!(因为自绘图案需判断是否可以掐丝)
A. 富士山:★☆☆☆☆ 1颗星|简单易完成
https://cdn.store-assets.com/s/181647/f/13829568.png
B1. 窗花款(圆角):★★☆☆☆ 2 颗星|难易适中,易完成
https://cdn.store-assets.com/s/181647/f/13829558.jpg
B2. 窗花款(尖角):★★☆☆☆ 2.5 颗星|难易适中,易完成
https://cdn.store-assets.com/s/181647/f/13829559.jpg
C1. 观叶款:★★★☆☆ 3 颗星|难易适中,成就感高
https://cdn.store-assets.com/s/181647/f/11419092.jpg
C2. 观叶款:★★★☆☆ 3 颗星|难易适中,成就感高
https://cdn.store-assets.com/s/181647/f/11419103.jpg
D. 鱼池款:★★★★☆ 4 颗星|有挑战度与成就感
https://cdn.store-assets.com/s/181647/f/13829570.png
E. 海浪款:★★★★★ 5 颗星|高挑战度,建议有相关金工经验再选择
https://cdn.store-assets.com/s/181647/f/13829561.png
**工作坊地址:**DIY School 手作体验
北市民生东路二段 119 号 2F-4
- 北捷行天宫站 1 号出口 右转步行 3 分钟
- 公车站:北捷行天宫站/ 松江民生路口
https://cdn.store-assets.com/s/181647/f/11458207.jpg
活动内容
注意事项
**★退费相关:**
|12 岁以上小朋友方能参加工作坊。
|由于场地空间座位有限,所以无法擕伴在旁等待,请您见谅。
https://cdn.store-assets.com/s/181647/f/11458187.jpg
其他信息
- 问题回报
- 我要检举此商品